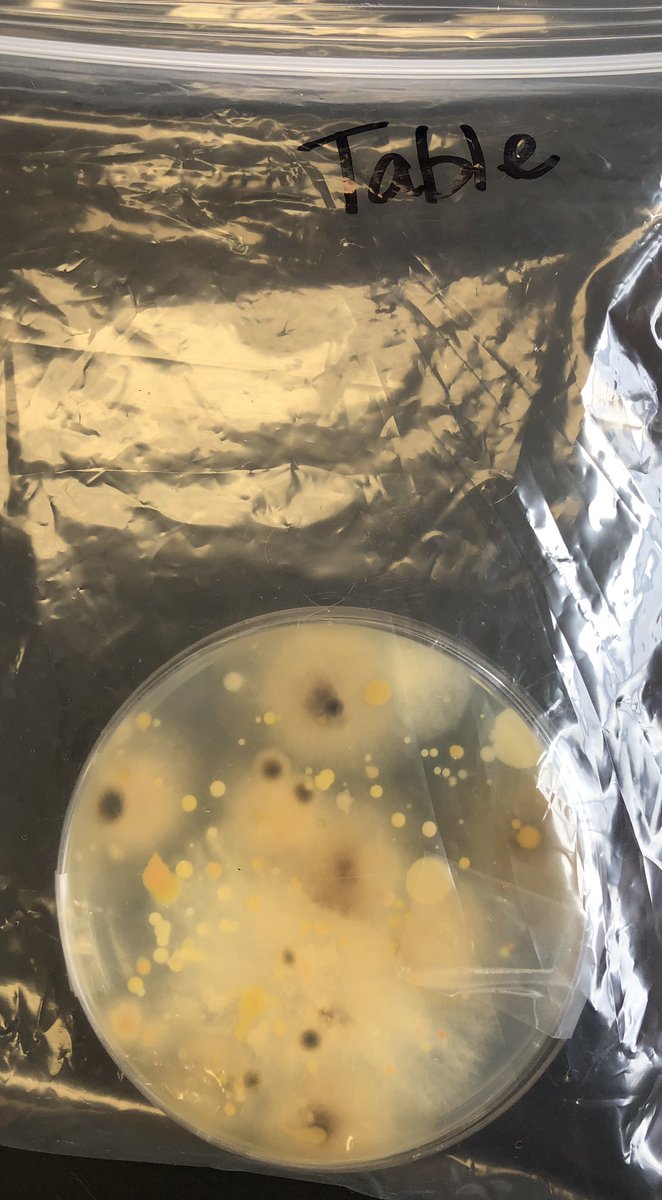
Having fun grossing 7th graders out as we learn. Lots of curiosity today! #wcjhhowlout <a href="/ryan_saam_AP/">Ryan Saam</a>

Jennifer Vacek
@jennvacek
ID: 3513613582
01-09-2015 14:55:45
159 Tweet
103 Followers
87 Following

Using QR codes to create food chains in the lab with 3rd grade! #ilovesse Stan C. & Patsy Stanley Elementary School #twitterbattle19 #kranzblue


The Stanley Garden Club has done an outstanding job to create a beautiful place for all kinds of creatures. Stan C. & Patsy Stanley Elementary School #ilovesse #butterfliesandladybugs




I literally love Jose Altuve !!!!!!!

Squishy circuits in the lab today! #ilovesse Stan C. & Patsy Stanley Elementary School #goAstros #takeitback



Looking forward to my trip to Texas A&M Hotel. For friends traveling soon: flip.to/r/r3aa Texas A&M Hotel and Conference Center Texas A&M Hotel and Conference Center


Today is Elf’s day in kindergarten here Stan C. & Patsy Stanley Elementary School. Guess who came to visit. #ilovesse #elfontheshelf Jennifer Vacek




Hands on learning in the best place ever! Exploring the Texas A&M gardens! #STEM4innovation Spark! PK-12 Engineering Education Outreach